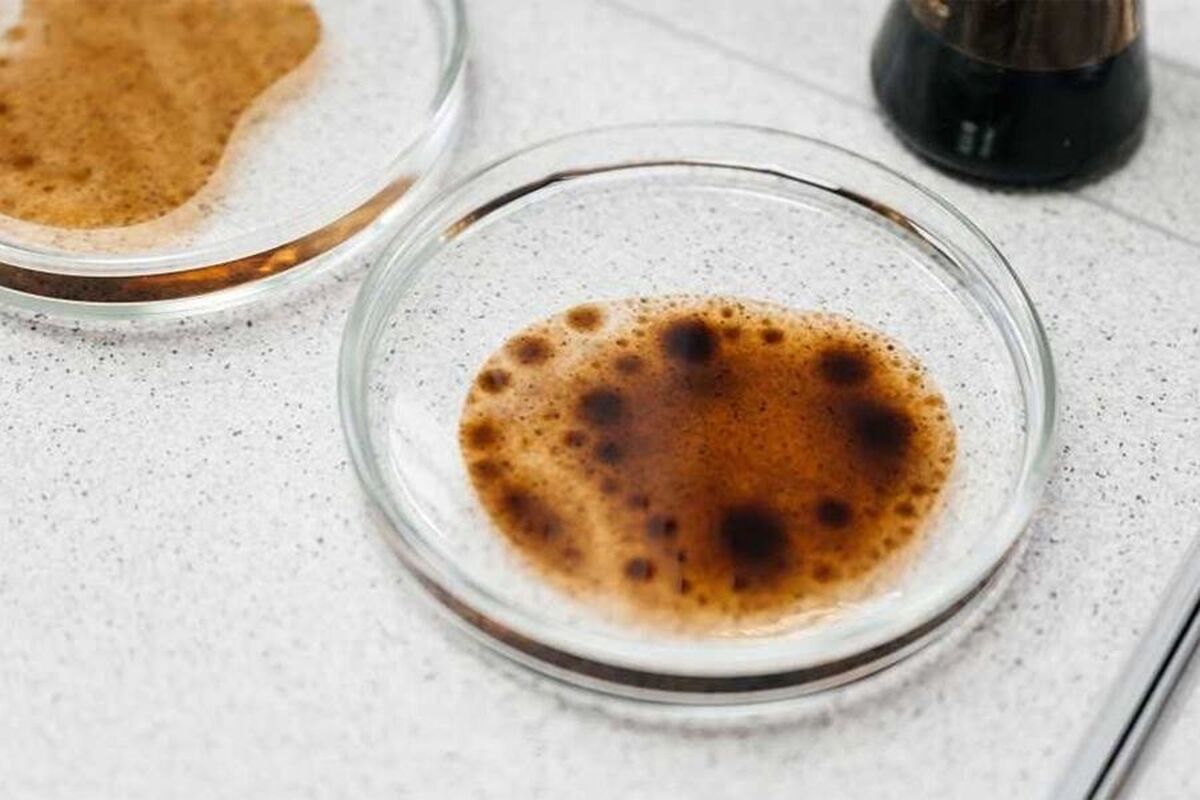
دانشمندان راز یک باکتری دریایی که نفت را تجزیه میکند، کشف کردند

- ارتباط با ما
- |
- درباره ما
- |
- نظرسنجی
- |
- اشتراک خبری
- |
- نگارنامه
دانشمندان راز یک باکتری دریایی که نفت را تجزیه میکند، کشف کردند
به گزارش مجله خبری نگار، دانشمندان آلمانی از دانشگاه بن و سایر مراکز تحقیقاتی، مکانیسمی را که باکتری دریایی Alcanivorax borkumensis به طور مؤثر لکههای نفتی را تجزیه میکند، رمزگشایی کردهاند. این مطالعه در مجله علمی Nature Chemical Biology (NCB) منتشر شده است.
جلبک Alcanivorax borkumensis از نفت تغذیه میکند و پس از نشت نفت به سرعت تولید مثل میکند و در بسیاری از موارد پاکسازی آلودگی را تسریع میکند. این جلبک این کار را با تولید یک "مایع ظرفشویی ارگانیک" انجام میدهد که از آن برای اتصال خود به قطرات نفت استفاده میکند.
کارشناسان خوشه ژنتیکی مسئول این فرآیند را شناسایی کردند. باکتریها یک بیوفیلم روی سطح قطرات نفت تشکیل میدهند. "عامل تمیزکننده" آنها مرز بین آب و نفت را مختل میکند و به میکروارگانیسمها اجازه میدهد آلکانها - اجزای اصلی نفت - را مصرف کنند.
وقتی این مکانیسم غیرفعال شد، Alcanivorax borkumensis ۸۰ درصد از اثربخشی خود را از دست داد. دانشمندان همچنین موفق شدند این خوشه را به سایر میکروارگانیسمها منتقل کنند و "روغنخوارهای" مصنوعی ایجاد کنند.
به گفته محققان، این کشف میتواند انقلابی در نحوه مبارزه با بلایای زیستمحیطی ایجاد کند.
- لطفا از نوشتن با حروف لاتین (فینگلیش) خودداری نمایید.
- از ارسال دیدگاه های نا مرتبط با متن خبر، تکرار نظر دیگران، توهین به سایر کاربران و ارسال متن های طولانی خودداری نمایید.
- لطفا نظرات بدون بی احترامی، افترا و توهین به مسئولان، اقلیت ها، قومیت ها و ... باشد و به طور کلی مغایرتی با اصول اخلاقی و قوانین کشور نداشته باشد.
- در غیر این صورت، «نگارمگ » مطلب مورد نظر را رد یا بنا به تشخیص خود با ممیزی منتشر خواهد کرد.




- آخرین اخبار
- محبوب
- برچسب های داغ
- ویدئو| «ترامپ چاپلوس»: بنیانگذار بناند جری پس از ممنوعیت «طعم غزه» صاحبان شرکتها را به چالش میکشد
- روانپزشکان یک مورد نادر از روانپریشی مرتبط با چرخه قاعدگی را ثبت کردهاند
- لحظهای که هواداران فوتبال منتظرش بودند! کریستیانو جونیور چه زمانی به پدرش در تیم اصلی النصر ملحق خواهد شد؟
- یک متخصص تغذیه این افسانه را که نباید بعد از ساعت ۶ بعد از ظهر غذا خورد، رد کرد
- مشهورترین رمز جهان حل شد
- دانشمندان راز عذرخواهی بینقص را فاش کردند
- سازمان بهداشت جهانی: خودکشی عامل یک درصد مرگ و میرها در جهان است
- JoHS: دانشمندان ویژگیهای شخصیتی مشترکی را در بین افراد صد ساله شناسایی کردهاند
- چگونه از روی وضعیت ابروهای یک فرد بفهمیم که او مشکل سلامتی دارد
- دروازهبان اینترمیلان با ماشینش به یک مردی که روی ویلچر نشسته بود، زد و جان باخت
- چه زمانی سردرد نیاز به مراقبت فوری پزشکی دارد؟
- هشدار مطالعه: ورزش شدید میتواند به قیمت جان زنان تمام شود!
- دانشمندان محصولی را شناسایی کردهاند که کیفیت زندگی صمیمی را بهبود میبخشد
- غذاهای غیرمعمول که با چین و چروک و افتادگی پوست مبارزه میکنند
- هزاران متجاوز جنسی در مشهورترین شهر آمریکا زندگی میکنند و ساکنان را به وحشت میاندازند
- سازمان بهداشت جهانی: تا ۳۰ سال آینده از هر چهار نفر، یک نفر دچار مشکلات شنوایی خواهد شد
- ویدئو| مسی نامزد جایزه معتبر MLS شد
- دانشمندان فاش کردهاند که چرا نباید دوستان را با شریک عاطفی جایگزین کنید
- مطالعه: پیادهروی فقط دو بار در هفته میتواند عمر زنان را طولانیتر کند
- قهرمان UFC ابراز تمایل کرد که با ارلینگ هالند، فوتبالیست، تمرین کند
- حل معمای پیدایش آب روی زمین به کمک ماه!
- چطور میتوان ظرفها را تمیز شست؟
- فشار خون به فصل ارتباط دارد؟
- رشد دوباره مو در سلولهای چربی نهفته است!
- درختان کهنسال گلدان دار میشوند!
- تنفس مصنوعی از راه روده!
- درمان سرطان تخمدان با کمک یک گیرنده سطح سلولی!
- علائم بروز سکته مغزی! + نقش مهم زمان!
- یک فنجان آب انار ضامن سلامت قلب!
- چگونه سالم لاغر شویم؟
- ثروتمندترین افراد جهان با هوش مصنوعی پولدارتر شدند!
- مولکولی که میتواند گرسنگی را از بین ببرد!
- اپل روند ساخت آیفون را تغییر میدهد!
- حسگری که افزایش اشعه خطرناک UV را هشدار میدهد!
- رفتار عجیب زنبورهای عسل در مقابل ملکه!
- رکورد طولانیترین مدت بقا با کلیه خوک شکسته شد!
- کارایی پردازش مدلهای زایا با این شتابندهها افزایش مییابد!
- پیشگیری از ابتلا به سرماخوردگی با سادهترین نکات!
- دوچرخه برقی برای پاها! عنوان پروژه جدید شرکت نایکی!
- افزایش عمر گوشی با ۷ ترفند ساده!
- زنان دو برابر مردان مستعد افسردگی هستند!
- عینک هوشمندی که بینایی نابینایان را بازمیگرداند!
- استویا میتواند راهی برای درمان کچلی باشد!
- دلیلی که باید به نوزاد بادام زمینی بدهید!
- افزایش دمای زمین باعث مرگ میشود؟
- داغی و سوزش کف پا نشانه چه بیماریهایی است؟
- بیماریهای قلبی و عروقی چه مقدار کشته میدهند؟
- فضای حافظه گوشی را میتوانید از طریق واتساپ مدیریت کنید!
- ایلان ماسک همچنان هوش مصنوعی و رباتها را چیره بر انسانها دید!
- چتباتهای هوش مصنوعی میتوانند توهم ایجاد کنند!
- معرفی بهترین زمان مصرف امپرازول و پنتوپرازول
- الگوریتم هوش مصنوعی میتواند خطر ابتلا به بیماریهای قلبی را عددی بیان کند!
- کمخونی ناشی از فقر آهن با این مکمل ترکیبی درمان میشود!
- روشهای فوری و معجزهآسای لاغری قابلیت عملی شدن دارند؟
- در زمان اسهال چی بخوریم؟
- پیرگوشی تحت تاثیر چه عواملی ایجاد میشود؟
- خاصیت لبو برای نوزادان و کودکان!
- بلعیدن آدامس خطرات ترسناکی دارد؟
- فیناستراید دارویی که باعث ایجاد افکار خودکشی میشود!
- داروهای مسکن و تببر استامینوفن برای دوران بارداری خطرناک است؟
- نوشیدنیهای انرژیزا میتوانند عامل خودکشی باشند!
- شش ترکیب پرمصرف که برای سلامتی مضرند!
- مصرف طولانی مدت امپرازول عوارض دارد؟
- نگهداری سیر تازه در روغن خطرناکترین روش است!
- یک نشانگر زیستی درمانی جدید برای سرطان تخمدان!
- درمان مشکل ضربان قلب با کمک پرتودرمانی!
- مهمترین عامل در بروز سکتههای مغزی چیست؟
- بسیار از سرطانها در مراحل اولیه قابل درمان هستند!
- اگر بیماری پرفشاری خون دارید، برای مصرف داروها به این نکات نیاز دارید!
- استنشاق گاز قرص برنج هم خطری است؟
- بیماری پسوریازیس باید سریعا تشخیص داده شود!
- بررسی اثرات فشار خون در فصل پاییز!
- آلرژی کودک به این آجیل را اینگونه از بین ببرید!
- مصرف مواد غذایی کپکزده خطر سرطان دارد!
- آمار عجیب ابتلای افراد به سکته مغزی!
- دید دقیق قویترین رصدخانه فضایی جهان واضحتر میشود!
- چگونه دمای دقیق بدن را اندازهگیری کنیم؟
- کرمی که بعد از ۴۶ هزار سال یخزدگی زنده شد!
- ساخت نمونه اولیه یک دستکش هوشمند تایید شد!
- فضای باز اعتماد به نفس کودک را زیاد میکند!
- همسر سابق آرشاوین: او بنتلی من را فروخت، یک مرسدس خرید و مابهالتفاوت را برای خودش نگه داشت
- مسی بهترین ورزشکاران در بین تمام رشتههای ورزشی را انتخاب کرد
- دلیل پاملا اندرسون، ۵۶ ساله، برای کنار گذاشتن آرایش
- جانیک سینر و کیلیان امباپه در رستورانی در پاریس با هم آشنا شدند
- خاطرات قربانی اپستین، افشاگری تکاندهندهای را در مورد شریک زندگی او و یک بازیگر بینالمللی آشکار میکند
- ستاره سریال «بازی تاج و تخت» با نامزد سابق داکوتا جانسون قرار ملاقات میگذارد
- همسر بیبر درباره درمانهای صورتش صحبت میکند
- تیماتی یکی از گرانترین ماشینها را به نامزدش داد
- حمله همسر وزیر بهداشت آمریکا به دلیل «رسوایی پیامکهای جنسی» به یک روزنامهنگار مشهور
- هایدی کلوم به مناسبت تولد ۱۶ سالگی دخترش، عکسی کمیاب از او در کنار دخترش منتشر کرد
- رشفورد نتوانست بین مسی و رونالدو یکی را انتخاب کند
- مودریچ برای همه بازیکنان میلان آیفون خرید تا مجبور نباشد جلوی تیم آهنگ اجرا کند
- عکس| واکنش همسر یاسر الزبیری پس از قهرمانی مراکش در جام جهانی زیر ۲۰ سال فیفا
- نیکول کیدمن ۵۸ ساله راز زیبایی خود را فاش کرد
- شاهزاده اندرو به ارتباط با اپستین در بریتانیا متهم شده است
- جیجی حدید علناً خطاب به بردلی کوپر گفت: «عشق من»
- برد پیت رابطهاش با اینس د رامون را به سطح بالاتری برد
- مگان مارکل عکسی از خودش و دخترش را به اشتراک گذاشت
- پاسخ شاهزاده هری به اتهامات همسرش مبنی بر بیاحترامی به مادرش فاش شد
- دختر ۱۴ ساله بکهام برند لوازم آرایشی خودش را تأسیس خواهد کرد
- جزئیات رابطه جنیفر لوپز و بن افلک پس از تجدید دیدار فاش شد
- عکس| دمبله برای جشن گرفتن بردن توپ طلا، یک جفت کفش اختصاصی دریافت کرد
- شایعات عاشقانه جرد لتو قوت گرفت
- پدری، هافبک بارسلونا، با قرار دادن یک بازیکن سابق رئال مادرید در فهرست خود، فوتبالیست ایدهآل را انتخاب کرد
- کیتی پری سکوت خود را در مورد رابطهاش با نخستوزیر سابق کانادا شکست
- بردلی کوپر مشکوک به جراحی پلاستیک است: "قبلاً بهتر بود"
- «لئو از صحبتهای شخصی خوشش نمیآید.» دییونگ توضیح داد که چطور از مسی تعریف و تمجید شده است
- مشخص شد که چرا خانواده بکهام در عروسی سلنا گومز شرکت نکردند
- پاریس هیلتون هفتهای ۹ ساعت را صرف مراقبتهای صورت میکند
- همسر جاستین بیبر توضیح داد که چرا او و این خواننده پسرشان را به نمایش نمیگذارند
- شوهر ستاره جیمز باند دستگیر شد
- همسر بیبر فاش کرد که با یک میلیارد دلار حاصل از فروش برندش چه خواهد کرد
- کیم کارداشیان دلیل طلاقش از کانیه وست را فاش کرد: "حمله دیگری اتفاق افتاده است"
- کیم کارداشیان با اعتراف به اینکه از قیمت مواد غذایی خبر ندارد، طرفدارانش را شوکه کرد
- بریتنی اسپیرز همسر سابقش را به قلدری متهم کرد: «دیگر بس است»
- شارلیز ترون به خاطر بیاحترامی به جانی دپ مورد انتقاد قرار گرفت: "او بیادب است. "
- کیث اربن پس از جدایی از نیکول کیدمن، رابطه عاشقانه جدیدی را آغاز کرده است: «او در شوک است.»
- مادر سلنا گومز به شایعات مربوط به رسوایی در عروسی دخترش پاسخ داد
- همسر بروس ویلیس گفت فرزندانش از همین حالا برای پدرشان سوگواری میکنند
- هواداران نیکول کیدمن پس از انتشار خبر طلاق، به کیت اربن حمله کردند
- فائزه العماری از مبارزه امباپه با شهرت میگوید
- بوفون در مورد انتخاب پسرش برای بازی در تیم ملی جمهوری چک: در ایتالیا، بار نام خانوادگیاش او را خرد میکرد
- پیشخدمت پرنسس دایانا راز جدیدی را در مورد کاخ باکینگهام فاش کرد
- پسر ۲۱ ساله راسل کرو به خاطر تصویرش مورد انتقاد قرار گرفت: «او مثل پدرش نیست.»
- نیکول کیدمن پس از جدایی از کیث اربن بیانیهای صادر کرد
- مگان مارکل به خاطر تمسخر یک مدل محکوم شد: «این حرفها خیلی گویای شخصیت واقعی اوست»
- ویکتوریا بکهام میگوید به خاطر شوهرش لبخند نمیزند
- جنیفر آنیستون اعتراف کرد که ۲۰ سال برای بچهدار شدن تلاش کرده است
- آنجلینا جولی، ستاره بینالمللی، درباره طلاقش از برد پیت، بازیگر مشهور، صحبت کرد و شکایت جدیدی علیه او مطرح کرد
- این دوچرخه سوار اسپانیایی تادژ پوگاچار را با بارسلونا یوهان کرایف مقایسه کرد
- کیت میدلتون با کت و شلوار سبز با "شکلات دبی" مقایسه شد
- جورج کلونی برای اولین بار درباره مصرف مواد مخدر صحبت کرد: «مشکلی نبود»
- شایعات نامزدی هرمیون گرنجر، ستاره هری پاتر، قوت گرفت
- «مدت زیادی تحریک و تحقیر شدم.» لروی سانه در اکتبرفست دعوا راه انداخت
- رایت: اگر کین از بایرن به تاتنهام برگردد، رکورد گلزنی شیرر در لیگ برتر را خواهد شکست
- رپر معروف، دیدی، به ۵۰ ماه زندان محکوم شد
- تام هالند برای اولین بار نامزدی خود با زندایا را تایید کرد
- نیکول کیدمن و کیث اربن جدایی خود را اعلام کردند
- حبیب پدرش را با سر الکس فرگوسن افسانهای مقایسه کرد
- مادر حدید، مدل معروف، مزرعه خانوادگیشان در پنسیلوانیا را برای فروش گذاشته است
- حمایت بانکها از بازار سرمایه از فردا اجرا میشود
- بورس سقوط کرده در دولت روحانی چگونه در دولت شهید رئیسی احیا شد؟
- درمان بورسی پزشکیان از زبان عبده
- جذب سرمایه ۷ همتی از بازار بورس دانشبنیانها
- وعده عناب بورسی واقعیتر شد
- چهارمین روز نزولی بازار در غیاب نیروهای صعودی
- انتخابات و دامنه نوسان مهمترین دلیل رکود فعلی بورس
- بورس با ۴ مصوبه دولت برای حمایت از بازار سهام سبزپوش میشود؟
- ۳ دلیل پایین بودن ارزش معاملات خرد در بورس
- معافیتهای مالیاتی بازار سرمایه باید استمرار پیدا کند
- بورس این روزها تحت تأثیر تداوم نرخ اخزای بالای ۳۵ درصد
- رشد شاخصهای بورس با کف سازی تکنیکال
- کاهش دامنه نوسان هم علاج بورس نزولی نبود
- سایه تامین مالی دولت بر سر بورس سنگینی میکند
- کاهش بی سابقه حجم معاملات سهام در بورسهای جهانی
- رشد شاخصهای بورس با کمک بانکیها و اعلام نرخ تسعیر ارز
- حمله به سفیر روسیه در لهستان
- معرفی سری گوشیهای Redmi K ۵۰ قبل از رونمایی رسمی
- غفوری: فکر کردن به قهرمانی از الان، سادهلوحانه است
- کاهش ۱۰ درصدی تولید هوندا در دو کارخانه
- سومین نشست دستمزد، باز هم بدون نتیجه
- لغو بلیت فروشی عمومی المپیک زمستانی چین
- گرامیداشت قربانیان هواپیمای اوکراینی در دانشگاه تورنتو
- ادامه چانهزنی چهارگانه در وین
- صرفهجویی ۱.۶ میلیارد دلاری کمیته برگزاری المپیک و پارالمپیک توکیو
- محبوبترین رشته المپیک توکیو مشخص شد
- اعلام هزینه میزبانی توکیو از المپیک و پارالمپیک ۲۰۲۰،
- آذرتاج: هیات اقتصادی جمهوری آذربایجان به ایران میرود
- بررسی عملکرد ایران در المپیک؛ جایگاه چهارمی در آسیا
- پایان وضعیت اضطراری در کشور میزبان المپیک ۲۰۲۰
- دانشمندان اصول اولیه گفتار انسان را در شامپانزهها کشف کردهاند
- جو دوسر: بین غذا و پیشگیری: چگونه سلامت روده و استخوان را تقویت میکند؟
- خردل: طعمی متمایز و فواید شگفتانگیز برای سلامتی
- «استعداد درخشان» دختر جوان، وحشتناک شد
- زوجها برای به دنیا آوردن فرزند اول زیاد صبر میکنند؟!
- از تهران تا سئول نامتوازن بود؟!
- لذت و دلهره| پسانداز در شرایط بیثباتی اقتصای کشور معنایی دارد؟
- در و دیواری که گالری نقاش را رقم زدند
- شما خوشبختی رو چی معنی میکنید؟!
- فواید شگفتانگیز کاکائو برای سلامتی مردان
- سی تی اسکن خطر ابتلا به سرطان خون را افزایش میدهد
- مواد شیمیایی موجود در لوازم آرایشی سیستم ایمنی بدن را تضعیف کرده و تعادل هورمونی را به هم میریزند!
- سلامت خواب: منظم بودن، کلید خواب خوب است
- کشف عاملی که ممکن است باعث اختلال در سیستم ایمنی شود
- پزشک توضیح داد که چگونه طوفانهای مغناطیسی بر سلامت تأثیر میگذارند
- «آب مخصوص»: نوآوری ژاپنی برای مبارزه با چربی احشایی
- ملاقاتهای مکرر با دوستان و خانواده میتواند خطر مرگ زودرس را کاهش دهد
- محققان «حلقه گمشده» در بهبود قلب پس از حمله قلبی را آشکار کردند
- MMR: اضافه بار فیزیکی خطر عفونتهای حاد تنفسی ویروسی را حتی در افراد آموزش دیده افزایش میدهد
- کشف پروتئینی که به تشخیص یک سرطان جدی در زنان کمک میکند
- JAMA: سطح تحصیلات بر خطر ابتلا به بیماریهای قلبی عروقی تأثیر میگذارد
- کلینیک مایو: لنف ادم خطر ابتلا به سرطان را دو برابر میکند
- یک متخصص تغذیه بهترین منابع آهن و نحوه جذب آن را توضیح میدهد
- یک متخصص، مفیدترین تمرینات ورزشی برای مردان بالای ۴۰ سال را معرفی کرد
- eCM: وضعیت نادرست بیمار نتایج اندازهگیری فشار خون را تحریف میکند
- یک ماده شیمیایی در زیتون راز پیشگیری از بیماریهای مغزی و حافظه را در خود دارد
- سرطان پوست غیرملانومی کشندهتر از ملانوما است
- روسیه یک ماده زیست تخریب پذیر برای بهبود بازسازی استخوان تولید میکند
- کارشناسان آلمانی خواستار افزایش دورهای مالیات بر دخانیات برای جلوگیری از سرطان شدند
- دانشمندان ثابت کردهاند که جایگزینی کوتاهمدتِ نشستن با خواب برای قلب مفید است
- اردن: تصمیم برای جمعآوری لاک ناخن ژلهای از بازار، خشم رسانههای اجتماعی را برانگیخت
- Live Science: خندهی شدید میتواند باعث غش کردن شود
- JAMA: متخصصان قلب دوز مشخصی از نمک را شناسایی کردهاند که فشار خون را تا ۷ درصد کاهش میدهد
- خشونت جنسی یکی از نگرانیهای عمده زنان در اردوگاههای پناهندگان روهینگیا در بنگلادش است
- مصرف مکمل ویتامین D در دوران بارداری خطر ابتلا به آسم در کودکان را کاهش میدهد
- باکتریهای خفته در رسوبات چربی روی دیوارههای شریانی ممکن است باعث حملات قلبی شوند
- سه میوه و یک توت شناسایی شدهاند که به کاهش کلسترول "بد" کمک میکنند
- دیلی میل: متخصص تغذیه معایب گوشت گیاهی را فهرست میکند
- واکسن آزمایشی علیه تمام گونههای شناخته شده و آینده آنفولانزای مرغی
- کشف «مولکول» مسئول حافظه بلندمدت در مغز
- ارز
- طلا
- بورس
- تورم
- اخبار داغ
- ورزشی
- پربیننده
- پربحث
- فیزیکدانان نوع جدیدی از ابرروانکننده را کشف کردهاند: نانومسیرهایی برای اتمها
- شزنی راز مهار پنالتی امباپه در ال کلاسیکو را فاش کرد
- یک سناتور آمریکایی درباره مقیاس آزمایشهای هستهای در آمریکا صحبت کرد
- اسرار جدید سیاره زهره دانشمندان علوم سیارهای را گیج کرده است
- پادشاه بریتانیا پس از افشای رسواییهای جنسی شاهزاده اندرو، اقدامات لازم برای سلب عناوین و عناوینش را آغاز کرد
- مقامات عالی رتبه آمریکایی نقل مکان به پایگاههای نظامی را آغاز کردهاند
- مشخص شد که چرا گربهها معمولاً بیشتر از سگها عمر میکنند
- «کاملاً بسته»: الجزایر هرگونه تلاش برای از سرگیری صادرات گاز به اسپانیا از طریق مراکش را قاطعانه رد میکند
- زاخارووا اظهار داشت که اوکراین میخواهد یک فاجعه انسانی ایجاد کند
- «ترامپ اشتباه نمیکند» ... مسکو ماهیت آزمایشهای بوروستنیک و پوزیدون را روشن میکند: این یک آزمایش هستهای نیست
- لیورپول با بدترین رکورد جام حذفی این باشگاه در ۹۲ سال گذشته برابری کرد
- آنها کاملاً "بدون انتشار" نیستند... حقایق تکان دهنده در مورد اتومبیلهای برقی
- دانشمندان راز سلاحهای باستانی نزدیکترین خویشاوندان انسان را کشف کردند
- وزیر خزانهداری آمریکا نسبت به تشدید پیامدهای اقتصادی ناشی از تعطیلی دولت هشدار داد
- با پیشتازی عربستان سعودی، عرضه اولیه سهام خاورمیانه ۷۰۰ میلیون دلار جمعآوری کرد
- در چین، وبلاگنویسانی که مدرک دانشگاهی ندارند، از صحبت کردن در مورد موضوعات «جدی» منع شدهاند
- دانشمندان راز یک باکتری دریایی که نفت را تجزیه میکند، کشف کردند
- فیلیپوت: وزیر دفاع بلژیک که مسکو را تهدید کرد، «خطری برای جامعه» محسوب میشود
- «توافق آماده و پیشنهاد باز است» ... جزئیات پیشنهاد عربستان برای متقاعد کردن صلاح برای بازی در لیگ روشن فاش شد
- درخواست مسی برای پیوستن به یک باشگاه عربستانی رد شد
- «تنبلها و بیاستعدادها»: نحوه ارزیابی کارمندان توسط شرکتها با استفاده از هوش مصنوعی آشکار شد
- زاخارووا: روسیه از ونزوئلا در دفاع از حاکمیت ملیاش حمایت میکند
- زاخارووا: «ائتلاف کشورهای داوطلب» تمرکز خود را از حمایت نظامی کییف به اعمال فشار مالی بر روسیه تغییر میدهد
- لیتوانی پس از بسته شدن مرز، صدها کامیون خود را در بلاروس سرگردان گذاشت
- یک پزشک هشدار داده است که بیماری کزاز میتواند از طریق سیخ کباب منتقل شود
- لاوروف از گوترش خواست تا درباره تحریک «صحنهسازیشده» در پوچا تحقیق کند
- بانک مرکزی اروپا نرخ بهره را در سطح فعلی خود نگه میدارد
- کانادا قطعات سیستم موشکی به اوکراین اهدا میکند
- «زمین، مریخ و هزاران ماهواره را لرزاند»: پیامدهای یک طوفان خورشیدی قدرتمند آشکار شد
- رویترز: تعطیلی دولت آمریکا، فعالیتهای افبیآی را مختل کرده است
- چین قصد دارد تا سال ۲۰۳۰ فضانورد به ماه بفرستد
- آمریکا علت درگیری ناتو و روسیه را شناسایی کرده است
- اپل از شرکت چینی اوپو به اتهام جاسوسی شکایت کرد
- دانشمندان آخرین مانع تبدیل سلولز به سوخت زیستی را شکستند
- پدر ایلان ماسک درباره سفرهای مخفیانه پسرش به مسکو صحبت میکند
- روسیه، آمریکا را به تلاش برای ایجاد اختلال در روابط روسیه و ونزوئلا متهم کرد
- ترامپ درباره بحران اوکراین: گاهی اوقات باید به طرفین یک درگیری اجازه جنگیدن داده شود
- اوربان احتمال حمله به پالایشگاه نفت روسیه را رد نکرد
- افبیآی به دلیل تعطیلی دولت، تحقیقات خود را به حالت تعلیق درآورده است
- دانشمندان طرحی را برای شکار سیارات سرگردان در کهکشان راه شیری کشف کردهاند
- سرویسهای امنیتی روسیه از افزایش موارد اخذ تابعیت روسیه برای اهداف مجرمانه خبر میدهند
- فرناندو آلونسو، راننده فرمول یک، نام بازیکن رئال مادریدی که به او شباهت دارد را اعلام کرد
- از العلا تا دریای سرخ... عربستان سعودی آغوش خود را به روی ۵۰ میلیون گردشگر باز میکند!
- هند اعلام کرد که در حال بررسی پیامدهای تحریمهای آمریکا علیه روسیه است
- دانشمندان بهترین محصولات کشاورزی را برای زنده ماندن از گرسنگی در طول زمستان هستهای شناسایی کردهاند
- «آناناس نقطه اوج شب بود!» ... عکسهای صلاح از تماشای شکست «افتضاح» لیورپول جنجال گستردهای به پا کرد
- اروپا در حال تجربه یک وضعیت روانپریشی نظامی است| پس از آنکه بلژیک تهدید کرد مسکو را از نقشه جهان محو خواهد کرد، روسیه هشدار داد
- به لطف زومرها مفهوم «شادی مردان» را تغییر کرده است
- دانشمندان هشدار میدهند که نانوپلاستیکها به «اسب تروا» برای فلزات سمی تبدیل شدهاند
- مدودف: اژدر پوسایدون به معنای واقعی کلمه یک سلاح آخرالزمانی است
- رسوایی جنسی اپستین، همسر سابق شاهزاده اندرو را از یک کانال تلویزیونی محبوب کنار گذاشت
- پسکوف: برخی از جمهوریهای شوروی سابق در تلاشند تا ریشههای تاریخی مردم خود را برای اهداف کوتاهمدت پاک کنند.
- رسانهها: مجارستان به رسمیت شناختن حادثه بالن به عنوان یک اقدام جنگ ترکیبی را رد میکند
- مطالعه: پناهندگان در آلمان به طور فزایندهای احساس ناخوشایندی میکنند
- سرقت از موزه لوور: اعترافات ناقص و سرنوشت نامعلوم جواهرات به ارزش ۸۸ میلیون یورو
- امواج غولپیکر زیر آب، راز پیدایش اقیانوس اطلس را برای دانشمندان آشکار کردهاند
- خبرگزاری آکی: شرکت ملونی در مراسم افتتاحیه موزه بزرگ مصر لغو شد
- برزیل قانونی را با هدف تقویت حمایت آنلاین از خردسالان تصویب کرد
- هافپست: دانشمندان BCM راهی برای بهبود نعوظ بدون ویاگرا کشف کردهاند
- دموکراتها ترامپ را به تلاش برای کسب سود شخصی از پروژه تالار رقص کاخ سفید متهم میکنند
- مشخص شد که چین چگونه میتواند ناوهای هواپیمابر آمریکایی را از کار بیندازد
- «او قهرمان جهان نیست، اما من هستم.» مارکو ماتراتزی در مورد مقایسه با ابراهیموویچ
- دانشمندان اعتراف کردهاند که تقریباً هیچ چیز در مورد اعماق اقیانوسهای زمین نمیدانند
- کارشناس: قیمت بیت کوین تا پایان سال میتواند به ۱۳۰ هزار دلار برسد
- آیا شاهزاده اندرو و سارا فرگوسن، شاهزاده بریتانیا، به دلیل رسوایی جنسی اپستین به زندان فرستاده خواهند شد؟
- روسیه از نظر تعداد میلیاردرهای دلاری به چهارمین کشور بزرگ جهان تبدیل شده است
- ایمونوتراپی برای مبارزه با سرطان در مراحل پایانی توسعه یافت
- اوکراین از تعطیلی سفارت خود در کوبا خبر داد
- جروم پاول: تعرفههای جدید آمریکا منجر به افزایش تورم در این کشور میشود
- ترامپ به کره جنوبی اجازه داده است که یک زیردریایی هستهای مدرن در آمریکا بسازد
- دانشمندان راز دیرینهای را در مورد قدرت تخمهای در حال سقوط کشف کردهاند
- «ما غیرممکن نمیخواهیم... ما فقط میخواهیم که فرزندانمان زنده بمانند» اسرائیل در عرض ۱۲ ساعت ۴۶ کودک را در نوار غزه شهید کرد
- یک هیئت نمایندگی کنگره آمریکا عازم مسکو است؛ لونا اعلام کرد که سرپرستی هیئتی را برای دیدار با نمایندگان دومای روسیه بر عهده خواهد داشت
- کره جنوبی ۳۵۰ میلیارد دلار برای کاهش تعرفهها به آمریکا پرداخت میکند
- ماهیگیران یک «شبح درخشان» جدید را در گودال ماریانا کشف کردهاند
- حمله تند هنرمند مشهور آمریکایی به ترامپ
- آلمان وضعیت زیرساختهای انرژی اوکراین را فاجعهبار خوانده است
- میزان مصرف ششلیک در روز اعلام شده است
- سفارت روسیه در مالی توصیه به ترک کشور برای مردم را تکذیب میکند
- آمریکا: معاون رئیس پلیس ایلینوی به جرم قتل یک زن سیاهپوست محکوم شد
- پنج گزینه برای جایگزینی مانوئل پلگرینی
- کریم آدیمی آیندهاش را پیچیده میکند
- مکرون به روند نزولی محبوبیت خود ادامه میدهد و از تمام روسای جمهور فرانسه که در ۵۰ سال گذشته محبوبیتشان کاهش یافته، پیشی گرفته است
- میکل آرتتا آینده مکس داونمن با استعداد را روشن میکند
- ساینس دایرکت: دانشمندان ایتالیایی راهی برای خوردن شیرینی کمتر پیشنهاد میدهند
- لوکاس پاکتا به این زودیها وستهام یونایتد را ترک نخواهد کرد
- جیمز رودریگز در پایان سال ۲۰۲۵ لئون را ترک خواهد کرد
- مسی پردرآمدترین بازیکن MLS است، سون دوم و بوسکتس سوم
- امضای شلوتربک هم حدی دارد!
- تاثیر قابل توجه جولیان آلوارز
- لیورپول در حال حاضر گزینهای را برای احیای خط حمله خود در نظر دارد
- کروس درباره حضور بارسلونا در ال کلاسیکو: وقتی رئال مادرید پرس کرد، آنها اینیگو را از دست دادند
- AS: مصدومیت پدری بدتر از حد انتظار بود| این بازیکن شش هفته از میادین دور خواهد بود
- هیئت مدیره اتحادیه بینالمللی فوتبال ممکن است قانون پرتاب اوت را تغییر دهد
- دلایلی که اندریک را به المپیک لیون سوق میدهد
- فدریکو کیهزا، از آیندهاش مطمئن است
- پنیا، دروازهبان الچه، در مورد پستهای یامال در شبکههای اجتماعی گفت: «بگذارید خوش بگذراند.»
- اوبی میکل در مورد صلاح: او سایهای از خود سابقش است| شنیدهام که مو خیلی به ژوتا نزدیک بود
- مشخص شد که آیا انزو مارسکا، سرمربی چلسی، ممکن است به یوونتوس برود یا خیر
- ولیکو پاونوویچ، آماده برای یک چالش جدید
- سه باشگاه بزرگ به دنبال رافائل لیائو هستند
- ناپولی همچنان به دنبال جذب کوبی ماینو است
- الکساندر گلب سختترین مسابقات قهرمانی جهان را نام برد
- آرسنال رکورد جدیدی در تاریخ فوتبال انگلیس ثبت کرد
- خواکین پانیچلی رویایی بلندپروازانه دارد
- حمله زمستانی برای جوئل اوردونز؟
- رئال مادرید به دنبال جذب بازیکن از آکادمی جوانان بارسلونا است
- ونسان کمپانی به پیروزی بایرن مقابل کلن در جام حذفی آلمان واکنش نشان داد
- ابراهیموف، بازیکن منچستر یونایتد، تابعیت ورزشی بریتانیایی خود را به روسی تغییر داده است
- اولین اقدامات لیون برای جذب اندریک!
- مارک گوی، در کانون توجه
- دو راه فرار برای جاناتان دیوید
- ارلینگ هالند، خرید ستاره
- یک دروازهبان چمپیونشیپ میتواند در تیم ملی انگلیس قرار بگیرد
- گاسپرینی، سرمربی رم، پس از بازی مقابل پارما گفت: «بعضی چیزها هنوز مشخص نیست.»
- فرانسه در صدر رتبهبندی درآمد حاصل از فروش بازیکنان آکادمی قرار دارد
- یانکوبا مینته باعث ایجاد شور و هیجان میشود
- ادن هازارد به تالار مشاهیر لیگ برتر راه یافت
- دوشان ولاهوویچ، عملیات استراتژیک
- مدافع تیم زیر ۲۱ سال انگلیس ممکن است ملیت ورزشی خود را تغییر دهد
- لیورپول از پایان ماه سپتامبر رکورد بیشترین شکست در پنج لیگ برتر اروپا را به نام خود ثبت کرده است
- سرمربی پاری سن ژرمن پس از بازی مقابل لوریان در لیگ ۱ فرانسه، از عملکرد تیمش انتقاد کرد
- باشگاه اتلتیک بیلبائو قصد دارد بازیکنان رایو وایکانو را به خدمت بگیرد
- تصمیم بزرگ رئال مادرید در مورد وینیسیوس جونیور
- موضع رئال مادرید در مورد آینده وینیسیوس مشخص شد
- آرن اسلات دلایل شکستهای اخیر لیورپول را نام برده است
- رادیموف در مورد احتمال پیوستن اسپالتی به یوونتوس گفت: «به همه کسانی که زیر نظر او بازی کردهاند حسادت میکنم.»
- ایلیمان ندای یک پیشنهاد ۵۵ میلیون یورویی را برانگیخت
- یه سطل آب سرد برای پدری!
- یک جایگزین غافلگیرکننده برای جناح چپ بارسلونا
- سرمربی کریستال پالاس درباره سومین پیروزی تیمش مقابل لیورپول در این فصل اظهار نظر کرد
- مسی توضیح داد که اینتر میامی برای قهرمانی در جام MLS چه کاری باید انجام دهد
- آرن اسلات: لیورپول حتی با بازیکنان اصلیاش هم بردهای زیادی مقابل کریستال پالاس نداشته است
- میلان گل دیگری را برای خط حمله خود به ثمر رساند
- لئو مسی اذعان کرد که بازنشستگیاش «به زودی فرا خواهد رسید»
- دوشان ولاهوویچ آیندهاش را در هالهای از ابهام قرار داده است
- میکل آرتتا در مورد پیروزی آرسنال مقابل برایتون اظهار نظر کرد
- هری کین در مورد پیروزی بایرن مقابل کلن: ما باید این روحیه را حفظ کنیم
- کاماوینگا، هافبک رئال مادرید، در مورد نقش خود در ال کلاسیکو مقابل بارسلونا کنایهای زد
- لوچانو اسپالتی اجازه میدهد خودش را دوست داشته باشند
- اتا ایونگ میخواهد در ژانویه تیم جدیدی انتخاب کند
- رویای ممنوعه بارسلونا برای جذب یک مهاجم ۱۰۰ میلیون یورویی
- دییونگ: اگر کارواخال میخواست با یامال صحبت کند، میتوانست این کار را خصوصی انجام دهد
- رافینیا در مورد صحبتهای یامال پیش از ال کلاسیکو: حرفهای او به رئال مادرید انگیزه داد
- میلان تمایلی به پیوستن پولیسیچ به تیم ملی آمریکا برای مسابقات ماه نوامبر ندارد
- سویا به دنبال ستاره جام جهانی زیر ۲۰ سال است!
- جانشین مارک گوئهی در منچسترسیتی است
- رئال مادرید از یوفا شکایت کرد و خواستار ۴.۵ میلیارد یورو غرامت شد!
- نویل درباره خط دفاعی لیورپول: آنها به وضوح مشکلات دفاعی دارند
- کارواخال و یامال یکدیگر را در شبکههای اجتماعی آنفالو کردند
- بروسیا دورتموند به دنبال یک استعداد آرژانتینی است
- رقابت شدید برای جذب بازیکن احتمالی منچسترسیتی
- آندرهآ برتا سه عملیات در آرسنال را تشریح کرد
- توتی درباره اسپالتی: او خرید بزرگی برای یوونتوس خواهد بود
- دفتر دادستانی، باشگاه بارسلونا را به دادگاه احضار کرده و درخواست پرداختهای اولیه در «پرونده نگریرا» را مطرح کرده است
- نونو مندس: من از نظر دفاعی خیلی قوی نبودم، اما انریکه خیلی به من کمک کرد
- لحظه اوج برای ترنت الکساندر-آرنولد
- ژائو نوس شور و اشتیاق را در انگلیس برمیانگیزد
- کانر گالاگر، تحت تعقیب
- مارکو ماتراتزی درباره شبیهسازی بوسکتس در بازی بارسلونا-اینتر در سال ۲۰۱۰ صحبت کرد



































































































